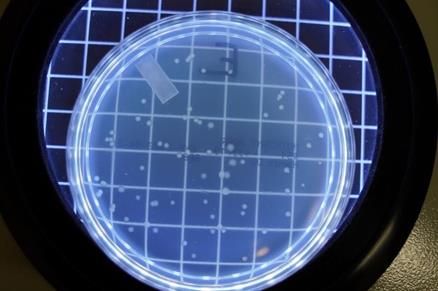

GermKiller 400 UV Air Cleaner helps prevent disease transmission in populated areas such as hospital waiting rooms.
During the beginning of the COVID-19 pandemic, our product development team saw a need for an ambient air cleaner that used UV light to help prevent disease transmission. After extensive product and market research, we concluded that the UV air purifiers on the market had issues with UV light leaks and lacked safety features that meet the Sentry Air standard. We wanted to provide a safer and more efficient solution. Exposure to UV light can cause damage to the eyes causing a condition called photokeratitis and damage to the skin such as sunburn or skin cancer (OSHA). It is important to minimize UV exposure especially in large applications or in areas with sensitive populations like hospitals or schools. After two years of development and extensive product testing, we are proud to introduce the Germ Killer UV Air Purifier.
About the Germ Killer UV Air Purifier
The Germ Killer UV Air Purifier utilizes a powerful airflow and UV light to help prevent disease transmission by aiding in deactivating airborne microorganisms. This system helps damage the DNA/RNA of viruses, bacteria, fungi, and other pathogens through ultraviolet germicidal irradiation. Ultraviolet germicidal irradiation aids in disinfecting the air or water by using UV lamps that emit short wavelength ultraviolet-C (UV-C) light in particular the 250 nm wavelength (Reed, 2010). By using shorter wavelengths, the UV light can better penetrate microorganisms and be more effective at stopping reproduction. This process helps reduce the reproduction of microorganisms and reduces the chance of infecting people with illnesses or ailments.
How the Germ Killer UV Air Purifier Works
The Germ Killer draws in infected air through an electrostatic pre-filter. The pre-filter helps prevent most of the large particles from entering the system which could reduce the UV light’s effectiveness. The air goes through the fan into the disinfection chamber where the air is exposed to UV-C light with reflective surfaces. Then, the system releases the processed air into the surrounding room through patent-pending light-shielding plenum and directional louvers. This innovative design helps prevent UV light leaks improving the overall safety of the system.
Applications of the Germ Killer UV Air Purifier
In general, the Germ Killer UV Air Purifier helps improve the air quality of heavily-populated locations such as schools, open workplaces, disease testing centers, hospitals, doctors’ offices, and more. These systems can also aid in reducing disease or microorganism transmission in disease laboratories, biology labs, and other labs that work with infectious materials.
Germ Killer Features and Benefits
The Germ Killer offers numerous features and benefits that allow operator customization and improve the UV light safety and efficiency. The Germ Killer provides powerful UV irradiance at 250 nanometers (nm) through two UV lamps. These high-intensity bulbs emit the UV-C light spectrum. This system offers an adjustable airflow that allows the operator to select a low speed of 300 CFM, a medium speed of 375 CFM, and a high speed of 450 CFM.
Safety Improvement Features
For the Germ Killer’s reduced UV light leak cabinet, we enhanced the design with safety features. First, the UV light chamber is separated from the air inlet with a filter, fan, and steel wall. Second, the single piece lid incorporates a design with less seams to reduce UV light leaks. This lid overlaps the cabinet by 1” to further prevent UV light leaks. Next, the air exits the system through an innovative light-shielding exit plenum and directional louvers. This outlet design helps prevent a direct line of sight with the UV light while minimally affecting the air pressure. Lastly, the system has a safety interlock that helps prevent the UV lamps from powering if the lid or filters are not properly in place.
Efficiency Features
The Germ Killer also offers design features that improve the overall system’s efficiency. First, the dual inlets have MERV 8 pre-filters to capture most of the medium and large particles. MERV 8 has an efficiency rating of 70% for particles 3.0 – 10.0 microns. By reducing the number of large particles in the system, the UV lamps and reflective surfaces will have less particle build-up and help prevent a reduction in efficacy. Next, the Germ Killer’s disinfection area features reflective surfaces on all 4 sides which helps improve the irradiance of the UV light and effectiveness of the system. Lastly, the Germ Killer offers a UV light sensor to monitor for a sufficient UV dose. The light sensor displays this information through two LED lights. The green LED light illuminates when the UV lamps are heated and ready, as well as when the system provides a sufficient UV dose. A red LED light blinks while the bulbs are heating and stays lit to indicate an issue with the system. This could mean the bulbs are burnt out or particle buildup has occurred on the bulbs requiring cleaning or service. The system should be serviced to ensure proper efficiency and operation.
Germ Killer UV Air Purifier Testing
The Germ Killer underwent stringent testing for UV, ozone, and the effectiveness of irradiance on bacteria. Results and testing methods are briefly discussed below.
UV Light Leaks/Irradiance Testing
To test the cabinet for light leaks, we conducted irradiance testing at different parts of the system: the intake, on the seam around the lid, and at the exhaust. UL requires UV devices to meet the maximum allowable escaping irradiance standard of 1 x 10-4 mW/cm2 (0.1 microwatt/cm2). The chart below shows the test results with the number on the chart corresponding to the numbered location on the drawing below.
Escaping Irradiance at Different Locations of Germ Killer
| # | Measurement Area | Irradiance (mW/cm2) | Irradiance (microwatt/cm2) |
| 1 | Control Side Intake | 5.6 x 10-5 mW/cm2 | 0.0560 microWatt/cm2 |
| 2 | Far Side Intake | 3.35 x 10-5 mW/cm2 | 0.0335 microWatt/cm2 |
| 3 | Lid | 4.5 x 10-5 mW/cm2 | 0.0450 microWatt/cm2 |
| 4 | Exhaust | 3.96 x 10-5 mW/cm2 | 0.0396 microWatt/cm2 |
From this testing, the Germ Killer’s maximum escaping irradiance or UV light leak was below the UL maximum in all areas where UV light could leak on the system. This testing proves that the UV cabinet/disinfection area has minimal light leaks.
Ozone Emission Testing
A 3rd party lab tested the Germ Killer ozone emission to optimize safety. Exposure to ozone can cause health side effects such as headaches, and nose, throat, and lung irritation especially for sensitive groups such as individuals with asthma or allergies (NIOSH, 2019). Because UV Air Purifiers are usually installed in locations with sensitive groups, it is vital to test for ozone to help protect safety and comfort for all. UL standards 867 and 2998 require maximum ozone emissions not exceed a concentration of 0.050 ppm and 0.005 ppm respectively (UL). The testing was conducted over an 8-hour period with the filter installed and the fan on high, low, and without the filter and the fan on high. Maximum emissions were found to not exceed 0.001 ppm. The chart below summarizes the testing’s findings.
Max Ozone Concentrations of the Germ Killer
| Fan Speed | Filter | Max Concentration C(t)max (ppm) |
| High | Yes | 0.001 ppm |
| Low | Yes | 0.001 ppm |
| High | No | 0.001 ppm |
Bacteria Irradiance Testing
To test bacteria irradiance efficiency, a motorized track (see picture to the left) was installed in the system to send a bacteria sample through the disinfection chamber in 1 second (Test 1 & 3) and 0.5 second (Test 2). These times were chosen to mimic the average time a particle stays in the chamber – 0.63 seconds. E. Coli samples were used after warming in an ice bath for 30 minutes and spread onto an agar plate. After being exposed to UV light, the samples were incubated at 37° C for 16 hours. Other samples were diluted with water in a 1:10 ratio per log to create log reductions and weren’t exposed to UV light. The diluted samples help provide a weighted average colony-forming unit (CFU) in order to estimate the number of bacteria. The following chart summarizes each of the test’s results including the estimated CFU, exposure time, irradiance, and resulting log reduction with the corresponding percent reduction.
Germ Killer Bacteria Testing Results
| Test # | CFU | Exposure Time | Humidity | Irradiance | Log Reduction | % Reduction |
| 1 | 155,166 | 1 second | 45% | 8 mJ/cm2 | >5.19 | >99.999356 |
| 2 | 63,333 | 0.5 second | 51% | 4 mJ/cm2 | >4.80 | >99.998421 |
| 3 | 2,528,333 | 1 second | 41 % | 8 mJ/cm2 | >6.40 | >99.999960 |
E Coli Samples With 4-Log Reduction and Most Growth
![]() Test 1 – Sample E 105 CFU |
![]() Test 2 – Sample E 70 CFU |
![]() Test 3 – Sample E 238 CFU |
E Coli Samples After UV Exposure
![]() Test 1 – Sample G 0 CFU |
![]() Test 2 – Sample G 0 CFU |
![]() Test 3 – Sample G 0 CFU |
This testing found the Germ Killer to be highly effective and provided at least 99.998421% reduction in E. Coli for the testing conditions. Results may vary.
The Germ Killer offers a safer and more effective solution for aiding in reducing disease transmission in heavily populated areas. Visit our website for more technical specifications of the Germ Killer. Contact us today to get started.
Related Blogs
• Improving Ventilation and Air Filtration to Help Prevent COVID Transmission in the Workplace
• Safety in the Science Classroom: Chemistry Fume Hoods and Air Cleaners
References
NIOSH. (2019, June 22). “Ozone.” Workplace Safety and Health Topics. Retrieved on October 18, 2022 from https://www.cdc.gov/niosh/topics/ozone/default.html
OSHA. “OSHA Technical Manual (OTM) – Section III: Chapter 6.” Directorate of Technical Support and Emergency Management. Retrieved on October 18, 2022 from https://www.osha.gov/otm/section-3-health-hazards/chapter-6
Reed, Nicholas. (2010). “The History of Ultraviolet Germicidal Irradiation for Air Disinfection.” Public Health Rep. Retrieved on October 18, 2022 from https://www.ncbi.nlm.nih.gov/pmc/articles/PMC2789813/
UL. “Safety Testing and Certification Services for Ultraviolet Radiation Devices.” Retrieved on October 18, 2022 from https://www.ul.com/services/zero-ozone-emissions-validation

Made in the USA